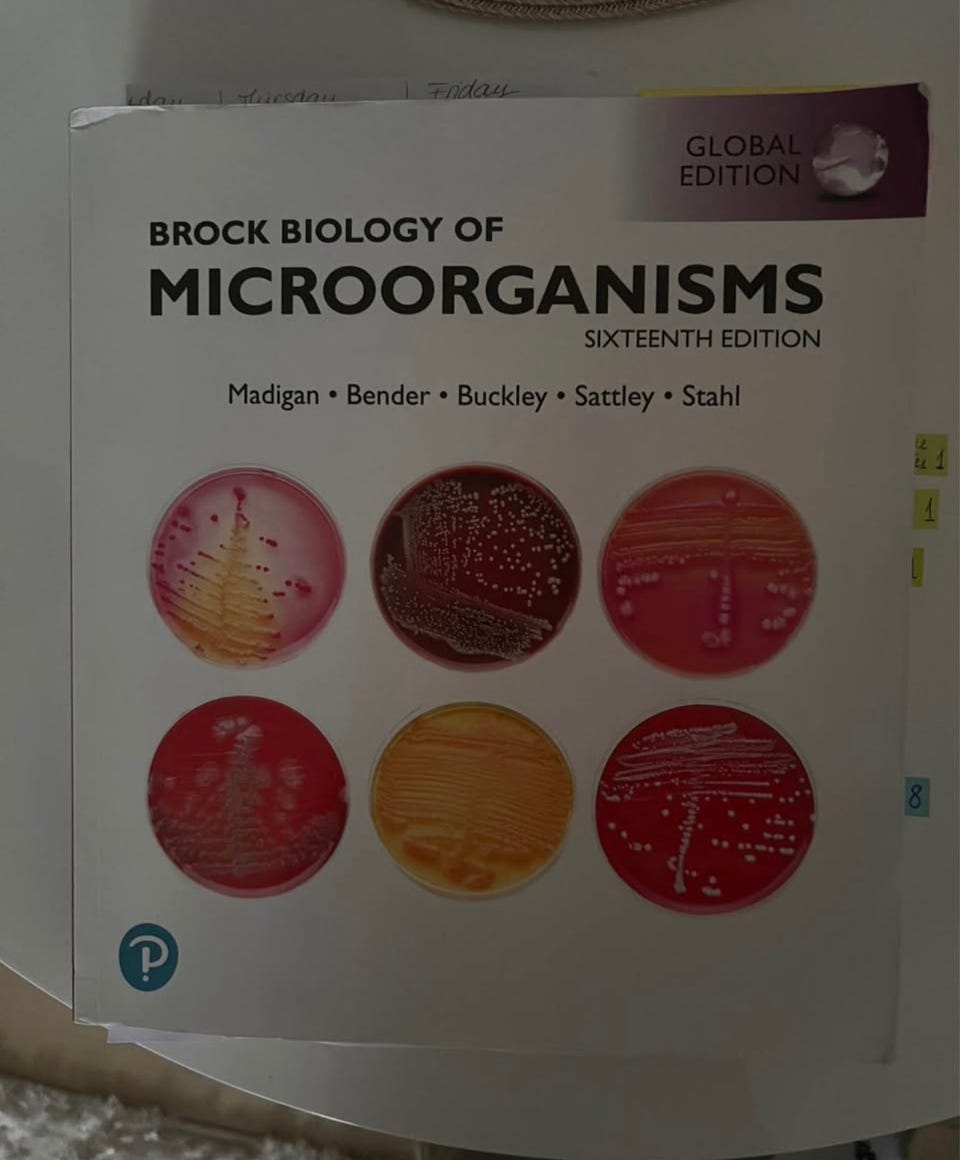
Galleribillede

Billedgalleri
Brock Biology of Microorganisms (16th Edition) – Global Edition
Til salg
Fragt fra 39,99 kr. + Tryg betaling 22 kr.
Tryg handel med Fiks færdig
Fiks færdig er DBA's nye betalings- og fragttjeneste. Efter levering har du 24 timer til at kontrollere varen, før pengene udbetales til sælgeren.
Varebeskrivelse
Stand: Brugt - men i god stand
For sale: A well-maintained copy of Brock Biology of Microorganisms, 16th Edition (Global Edition). This is a foundational textbook for microbiology, biotechnology, and medicine students.
Condition: Used but in good condition. The cover and spine are intact, and the pages are clean.
Authors: Madigan, Bender, Buckley, Sattley, Stahl.
Edition: 16th Edition.
Content: Renowned for its accuracy and impeccable illustrations, this book provides a thorough introduction to microbial ecology, metabolism, and genetics.
Perfect for students looking for a reliable copy at a fraction of the original retail price!
Brugerprofil

Du skal være logget ind for at se brugerprofiler og sende beskeder.
Log indAnnoncens metadata
Sidst redigeret: 6.4.2026 kl. 14:50 ・ Annonce-ID: 20276360